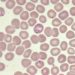
Malarial transmission substantially reduced in endemic Africa

1. Counseling and behavioral interventions to limit excess gestational weight gain was associated with decreased risk of gestational diabetes, emergency cesarean delivery, macrosomia, and large for gestational age babies.
2. Behavioral interventions aimed at promoting healthy weight gain during pregnancy were also associated with modest reductions in mean gestational weight gain and decreased likelihood of exceeding gestational weight recommendations.
Evidence Rating Level: 1 (Excellent)
Study Rundown: Gestational weight gain (GWG) is commonly defined as change in weight measured from pre-pregnancy or during the first trimester to just before delivery. In past observational studies, pre-pregnancy body mass index (BMI) has been found to be independently and strongly associated with adverse pregnancy outcomes. This review sought to summarize and synthesize the evidence on benefits and harms of behavioral interventions to promote healthy weight gain during pregnancy in order to inform the US Preventive Services Task Force recommendation (USPSTF). The main outcomes and measures of the review consisted of weight-related intermediate outcomes, maternal and infant morbidity and mortality, as well as general harms to pregnancy such as anxiety and depression. In total, 68 studies enrolling 25,789 participants were included. GWG interventions were associated with decreased risk of gestational diabetes (RR, 0.87; ARD, -1.6%), emergency cesarean delivery (RR, 0.85; ARD, -2.4%), macrosomia (RR, 0.77; ARD, -1.9%), and large for gestational age (RR, 0.89; ARD, -1.3%). The study found no significant association between GWG interventions and risk of gestational hypertension, cesarean delivery, preterm birth, or preeclampsia. Furthermore, patients who received behavioral interventions experienced reduced weight gain across all pre-pregnancy weight categories (pooled mean difference, -1.02 kg) and demonstrated lower likelihood of GWG in excess of the National Academy of Medicine (NAM) recommendations (RR, 0.83; ARD, -7.6%). One limitation of this study was that it did not address issues of health care disparities, access to prenatal care (or lack thereof), or feasibility of interventions in settings where access to care is limited or arrival to care is delayed. Further studies focusing on underrepresented populations who may have higher risk of adverse outcomes are needed.
Click to read the study in JAMA
Click to read an accompany editorial in JAMA
Relevant Reading: The effect of a counselling intervention on weight changes during and after pregnancy: a randomised trial
In-Depth [systematic review and meta-analysis]: This systematic review and evidence report for the USPSTF compiled data from Ovid MEDLINE and the Cochrane Library with surveillance through February 2021. In total, 68 studies were selected for the review, enrolling 25,789 participants. Of these, 67 studies evaluated interventions during pregnancy, and 1 evaluated an intervention pre-pregnancy. Randomized clinical trials (RCTs) and nonrandomized controlled intervention studies were considered for assessing harms while only RCTs were eligible for analysis in all other outcomes. The study found that GWG interventions were associated with reductions in risk of gestational diabetes (43 trials, n = 19,752; RR, 0.87 [95%CI, 0.79-0.95]; ARD, -1.6%), emergency cesarean delivery (14 trials, n = 7,520; RR, 0.85 [95%CI, 0.74-0.96]; ARD, -2.4%), macrosomia (25 trials, n = 13,990; RR, 0.77 [95%CI, 0.65-0.92]; ARD, -1.9%) and large for gestational age (26 trials, n = 13,000; RR, 0.89 [95%CI, 0.80-0.99]; ARD, -1.3%). In contrast, there was no significant association between GWG interventions and risk of gestational hypertension, cesarean delivery, preterm birth, or preeclampsia. Additionally, intervention participants experienced decreased weight gain across all pre-pregnancy weight categories (55 trials, n = 20,090; pooled mean difference, -1.02 kg [95%CI, -1.30 to -0.75]) and demonstrated lower likelihood of GWG in excess of NAM recommendations (39 trials, n = 14,271; RR, 0.83 [95%CI, 0.77-0.89]; ARD, -7.6%). Lastly, GWG interventions were associated with reduced postpartum weight retention at 12 months.
Image: PD
©2021 2 Minute Medicine, Inc. All rights reserved. No works may be reproduced without expressed written consent from 2 Minute Medicine, Inc. Inquire about licensing here. No article should be construed as medical advice and is not intended as such by the authors or by 2 Minute Medicine, Inc.